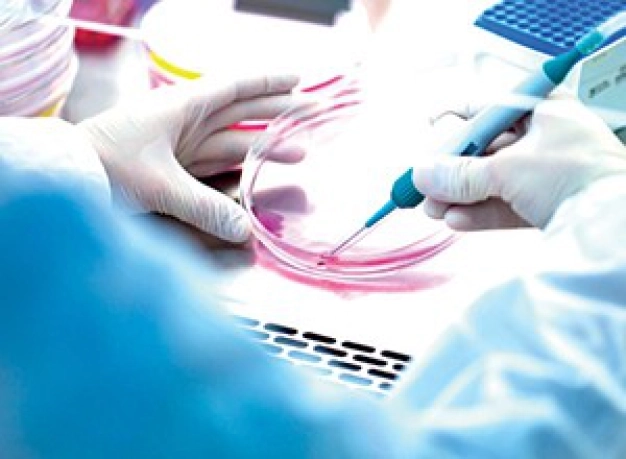
Tıpta endüstri hamlesi

- Son Dakika
- Gündem
- Ekonomi
- Finans Ekstra+
- Yazarlar
- Sektörel
- Dünya
- Kültür-Sanat
- Teknoloji
- FOTOĞRAF GALERİSİ
- VİDEO GALERİSİ
- e-Gazete
Gelişmelerden haberdar olmak için İstanbul Ticaret Haberleri uygulamasını indirin


HABER: CANAN BİLGİN
Biyoloji ve teknolojinin birleşimi ile kalp rahatsızlıklarından virüslere kadar pek çok sağlık sorunuyla mücadele etmemize yardımcı olan kök hücre araştırmaları ve nanoteknolojideki ilerlemeler, bizi yarı insan, yarı sentetik bir bilim-kurgu geleceğine mi hazırlıyor?
İngiliz yönetmen Ridley Scott’un büyük gişe rekorları kıran Bıçak Sırtı (Blade Runner) filminde insanoğlu, insana benzeyen, hareket eden, ses çıkaran, ancak tamamen sentetik malzemeden yapılmış bir kopya nesil için biyomühendislikten yararlandı. Bu bilimkurguyu gerçekleştirmekten henüz uzak olabiliriz ama sentetik ilaçlar tıpta derin bir etkiye sahip olmaya başlıyor.
İngiliz yayın kuruluşu BBC, sentetik ilaçların, kök hücre veya 3D baskı ile üretilen doku ve organların, hatta programlanabilir minik biyo-makine nanobotların, artık sadece bilim kurgu olmadığını ve çok yakın gelecekte organ naklinin yerini alabileceğini bildirdi.
İşte kavanozda kalplerden 3D yazıcılarda ‘basılan’ canlı dokulara, nanobotlardan ninja polimerlere kadar tıpta sanayi hamlesi…
6 AYDA YAPAY KALP
Kanadalı Novoheart şirketinden bilim adamları, Hong Kong’da en son teknolojiyle geliştirilmiş laboratuvarlarında, ‘kavanozda kalpler’ olarak adlandırdıkları biyo-yapay kalp üretmek için kök hücre kullanıyorlar. Prof. Ronald Li ve ekibi, kanınızın yalnızca 2.5 ml’inden kök hücre üretebiliyor ve onu sizinki gibi atan, yeni ilaçlara sizinki gibi tepki gösteren kalbinizin minyatür bir ‘klon’ versiyonuna dönüştürebiliyor. Tüm bu süreç 6 ay sürüyor.
MALİYETİ 2 MİLYAR DOLAR
Prof. Li, teknolojinin hayati derecede önemli olan yeni ilaçların gelişimini hızlandırabileceğine inanıyor; çünkü olası yan etkileri, insanların kullanımından önce tespit edilebiliyor. İlaç geliştirmenin çok uzun, yorucu ve pahalı bir süreç olduğuna dikkat çeken Prof. Li, “Tek bir ilacı geliştirmek 10 yıldan fazla sürüyor ve genellikle 2-3 milyar dolara mal oluyor. Çalışmaların yüzde 90’ı bazen başarısızlıkla sonuçlanabiliyor” diyor. Prof. Li, ilaç endüstrisindeki bu büyük riske işaret ederek, “Hastanın kendi kanından oluşturulan kök hücrelerle üretilen biyo-yapay organlar, organ naklinin geleceği olabilir. Kök hücreden üretilen dokular ve organlar artık sadece bilim kurgu değil” yorumunu yapıyor.
NAKİL YERİNE 3D DOKU
 Biyoteknoloji şirketleri, ‘kavanozda kalp’ üretmenin yanı sıra 3D yazıcılar kullanarak canlı dokular ‘basıyor’. Bu dokular da, deri veya eklemlere kıkırdak üretmek üzere kullanılabiliyor. Biyoteknoloji şirketleri, bu alandaki çalışmalarını ilerletmek için yatırımlara da ağırlık veriyor. Biyo-baskı uzmanı Aspect Biosystems, 3D baskılı diz menisküs dokusu geliştirmek için Johnson & Johnson ile ortaklık kurdu. Aspect Biosystems CEO’su Tamer Mohamed, “Önümüzdeki 10-15 yıl içinde, vücuda yerleştirilebilen 3D dokuları göreceğimize inanıyorum” diyor. Mohamed’e göre de biyo-baskı dokular gelecekte nakil için kullanılabilecek.
Biyoteknoloji şirketleri, ‘kavanozda kalp’ üretmenin yanı sıra 3D yazıcılar kullanarak canlı dokular ‘basıyor’. Bu dokular da, deri veya eklemlere kıkırdak üretmek üzere kullanılabiliyor. Biyoteknoloji şirketleri, bu alandaki çalışmalarını ilerletmek için yatırımlara da ağırlık veriyor. Biyo-baskı uzmanı Aspect Biosystems, 3D baskılı diz menisküs dokusu geliştirmek için Johnson & Johnson ile ortaklık kurdu. Aspect Biosystems CEO’su Tamer Mohamed, “Önümüzdeki 10-15 yıl içinde, vücuda yerleştirilebilen 3D dokuları göreceğimize inanıyorum” diyor. Mohamed’e göre de biyo-baskı dokular gelecekte nakil için kullanılabilecek.
NANOBOTLAR İŞ BAŞINDA
 Tıpta, sanayi hamlesini ortaya koyan bir diğer gelişme de nanobotlar; tıpkı kan hücrelerinin yaptığı gibi kanser hücrelerini ve bakterileri yok etmek için kan akışını düzenleyen programlanabilir minik biyomakineler. Arizona State University’den bilim adamları, Çin Bilimler Akademisi Ulusal Nanobilim ve Teknoloji Merkezi’ndeki araştırmacılarla işbirliği yaparak, tümörleri küçültmek için nanobotlar programladı. Söz konusu nanobotlar, mekanik parçalardan oluşan makine robotlarının aksine, DNA’nın şekiller içine katlanmasını içeren ‘DNA origami’ tekniğiyle tasarlandı. Ekip, ilk testte de başarılı oldu.
Tıpta, sanayi hamlesini ortaya koyan bir diğer gelişme de nanobotlar; tıpkı kan hücrelerinin yaptığı gibi kanser hücrelerini ve bakterileri yok etmek için kan akışını düzenleyen programlanabilir minik biyomakineler. Arizona State University’den bilim adamları, Çin Bilimler Akademisi Ulusal Nanobilim ve Teknoloji Merkezi’ndeki araştırmacılarla işbirliği yaparak, tümörleri küçültmek için nanobotlar programladı. Söz konusu nanobotlar, mekanik parçalardan oluşan makine robotlarının aksine, DNA’nın şekiller içine katlanmasını içeren ‘DNA origami’ tekniğiyle tasarlandı. Ekip, ilk testte de başarılı oldu.
Blade Runner filminde, insana benzeyen, hareket eden, ses çıkaran, sentetik malzemeden yapılmış bir kopya nesil için biyomühendislikten yararlanıldı.
VİRÜSLER YILDA 700 BİN CİNAYET İŞLİYOR
Antibiyotikler virüslerin yeni türlerine karşı etkisiz hale geldiğinde, sentetik ilaçlar devreye girerek, antimikrobiyal dirence karşı mücadelede öncülük edecek. İngiltere’de hazırlanan Antimikrobiyal Direnç Raporu’na göre, virüsler dünyada yılda yaklaşık 700 bin kişinin ölümüne neden oluyor. Rapora göre, mevcut antibiyotikler etkilerini yitirmeye devam ederse, 2050’ye kadar her yıl 10 milyon insan ölebilir.
NİNJA POLİMERLER
Tıptaki bir diğer gelişme de virüslerle mücadele eden sentetik bakteri öldürücüleri ninja polimerler. Kaliforniya’da IBM Araştırma’daki bilim adamları, Singapur Biyomühendislik Enstitüsü ve Nanoteknoloji Bilim Ajansı ile birlikte çalışarak beş ölümcül ilaca dirençli bakteriyi yok etmek için sentetik polimer geliştirdi. Ekibin fareler üzerinde gerçekleştirdiği testler sonucunda sentetik polimerler bakterileri yok etti. Araştırmaya öncülük eden Dr. James Hedrick, söz konusu teknolojiyi kanser tedavisi için de geliştirdiklerini ve ümit verici bir şekilde çok daha az yan etkisi olduğunu söylüyor.
‘TEKNOLOJİ DESTEĞİNDE GERİDE KALDIK’
The Medical Futurist Institute’un Direktörü Dr. Bertalan Mesko, endüstrinin çok uzun süre teknoloji desteğinden geride kaldığını belirterek, “Birçok endüstri 21. yüzyıla adım atmış olsa da, sağlık atmadı. Milyonlarca hasta doku, organ nakli için bekleme listelerinde. Piyasaya yeni ilaçlar sunmak için yapılan klinik denemeler bazen 10 yıl sürüyor ve milyarlarca dolara mal oluyor” diyor. Sentetik ilaçtaki ilerlemenin tedavi için umut vadettiğini belirten Dr. Mesko, “Dijital sağlık teknolojileri geliştiren şirketler, 21. yüzyıla sadece sağlık hizmeti vermekle kalmıyor, tedaviyi hedef haline getiriyor” yorumunu yapıyor.
The Medical Futurist Institute’un Direktörü Dr. Bertalan Mesko, endüstrinin çok uzun süre teknoloji desteğinden geride kaldığını belirterek, “Birçok endüstri 21. yüzyıla adım atmış olsa da, sağlık atmadı. Milyonlarca hasta doku, organ nakli için bekleme listelerinde. Piyasaya yeni ilaçlar sunmak için yapılan klinik denemeler bazen 10 yıl sürüyor ve milyarlarca dolara mal oluyor” diyor. Sentetik ilaçtaki ilerlemenin tedavi için umut vadettiğini belirten Dr. Mesko, “Dijital sağlık teknolojileri geliştiren şirketler, 21. yüzyıla sadece sağlık hizmeti vermekle kalmıyor, tedaviyi hedef haline getiriyor” yorumunu yapıyor.